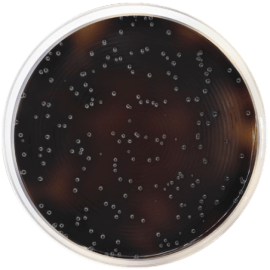
main product photo

Close
LISTERIA AGAR BASE OXFORD 500 grams/bottle
SKU
CDL/1133
Brand
CONDALAB
Pre-order (Deliver in 8 to 12 weeks)
Listeria Agar Base Oxford is a selective medium for Listeria according to the Oxford formula and it is recommended for the detection of Listeria monocytogenes from clinical samples and food products. It is used for a direct sample inoculation or for confirmation after using Listeria Enrichment Broth Base (Cat.1120).
All Listeria species hydrolyze the esculin to esculetin, which reacts with the iron ions producing black colonies and a blackening of the medium. Another advantage of this medium is that peptones and maize starch provides a rich nutrient base for growth, and the addition of Ferric ammonium citrate improves the growth of L. monocytogenes. Lithium chloride is an inhibiting agent, together with the other antibiotics from the supplement, which inhibit the growth of gram-negative bacteria and a large part of Gram-positive ones. Cycloheximide inhibits yeasts.
Listeria Agar Base Oxford is a selective medium for Listeria according to the Oxford formula and it is recommended for the detection of Listeria monocytogenes from clinical samples and food products. It is used for a direct sample inoculation or for confirmation after using Listeria Enrichment Broth Base (Cat.1120).
All Listeria species hydrolyze the esculin to esculetin, which reacts with the iron ions producing black colonies and a blackening of the medium. Another advantage of this medium is that peptones and maize starch provides a rich nutrient base for growth, and the addition of Ferric ammonium citrate improves the growth of L. monocytogenes. Lithium chloride is an inhibiting agent, together with the other antibiotics from the supplement, which inhibit the growth of gram-negative bacteria and a large part of Gram-positive ones. Cycloheximide inhibits yeasts.
| Brand | CONDALAB |
|---|
Write Your Own Review

Validate your login